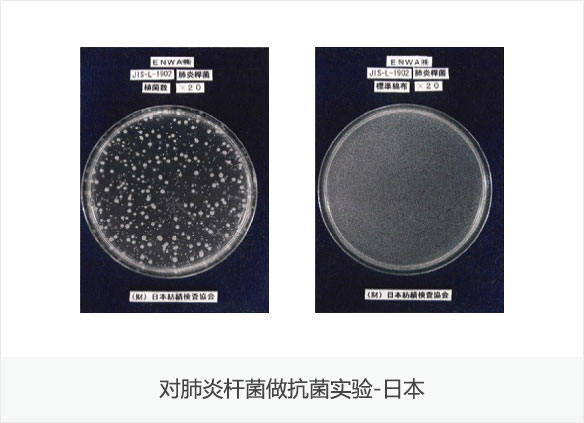

询问公司简介close
研发中心
专注研究水科学36年, 荣获总统颁布的第46届发明铁塔产业勋章!
抗菌,抗真菌效果
抗菌实验结果表明3%浓度的芬多精消灭了肺炎球菌。日本政府认证机关检查结果表明,芬多精有着广泛的抗菌能力,可以消除真菌,李斯特菌,沙门氏菌,0517菌,超级抗药性细菌,军团杆菌,白色念珠菌,葡萄球菌,肺炎球菌等。
去除甲醛的效果
入住后启用芬多精森林浴机器会明显降低室内甲醛的含量。如果持续使用,会帮您消除新家中因装修产生的所有有害化学物。

使学习能力向上的效果
芬多精有助于提高集中力和记忆力。吸入芬多精可以让您保持安定的状态,减少压力,提高智力和记忆力。